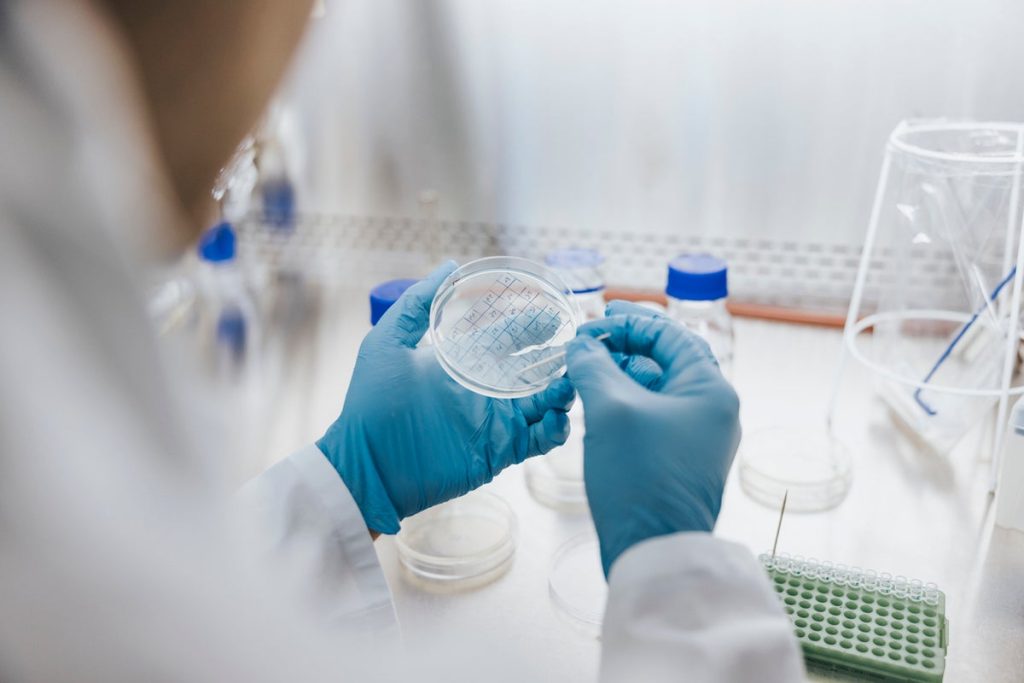

NYC pitbulls attack chihuahua in what could be the aggressive dogs’ second incident.

A troubling video captures the moment when two aggressive pit bulls attacked a 16-pound Chihuahua on the Upper West Side. Penny, a Chihuahua mix and service dog, is currently in intensive care following the incident that occurred unexpectedly at the corner of 86th Avenue and Columbus Avenue on Saturday night. The footage also reveals a […]
We need to reduce Medicaid payments for able-bodied individuals to be more in line with the rates for disabled and low-income children.

During Monday’s episode of Bloomberg’s “Balance of Power,” Rep. Byron Donald (R-FL) discussed the need for lower rates benefitting individuals with disabilities and low-income children. He emphasized the importance of eliminating waste, fraud, and abuse from Medicaid, which is a key point of their ongoing discussions. “Currently, under Medicaid, there’s a scenario where we can […]
Trump Directs Halt to Federal Support for ‘Risky’ Gain-of-Function Biological Research

An executive order signed by President Donald Trump on Monday has banned all U.S. funding for biological research in countries deemed risky, such as China and Iran. This decision is part of Trump’s broader initiative to enhance safety and security concerning biological studies, both domestically and internationally. The president has consistently supported the view that […]
New Setback for Trump Administration as Judge Rules to Allow 12,000 Refugees.

A judge has instructed President Donald Trump’s administration to take action regarding its impact on immigration policy in the U.S. This order adds clarity to the restrictions from the Court of Appeals, which had allowed the administration to halt the hospitalization process for refugees, yet mandated that individuals already recognized as refugees in their travel […]
Rep. Burgess Owens Criticizes Nike for Their Reported ‘Child Abuse’

Burgess Owens Calls Out Nike Over Allegations Burgess Owens is making his stance clear. Recent discussions from various outlets, including Daily Caller, have spotlighted sports apparel giant Nike and its supposed ties to funding research on young transgender athletes. Unlike some other media sources that are addressing the matter, most of Nike appears to be […]
Trump’s criticism of ActBlue breaches the First Amendment.

President Trump is at it again, this time targeting political opponents he accuses of fraud and corruption. His focus is on ActBlue, a prominent funding platform for Democratic candidates across various levels. Since its inception in 2004, ActBlue has raised nearly $17 billion for Democratic causes. In the 2024 election alone, it amassed over $1 […]
Congress Needs to Stop the Obama-Biden DEI Data Collection

The Biden administration has been under scrutiny for the significant deficits it has introduced into the U.S. economy, reaching nearly $2 trillion. One of the main criticisms targets the Consumer Financial Protection Bureau (CFPB) for its penchant for creating expensive regulations in the name of consumer protection. Specifically, the CFPB has implemented rules under Section […]
Alert about deadly fungus that may affect millions as it spreads throughout Europe
A recent study suggests that a dangerous fungus is likely to spread into new regions of Europe, triggered by rising temperatures associated with climate change. This fungus, known as Aspergillus, poses serious health risks, potentially affecting millions annually as it moves into northern areas of Europe, and other parts of Asia and the Americas. Norman […]
Aetna to leave the Affordable Care Act insurance market – AJC.com

Aetna’s Withdrawal from Georgia: Impacts and Concerns The withdrawal of Aetna from Georgia’s healthcare market could increase stress for rural residents trying to access affordable healthcare, according to Veazey. “We can only do that,” he noted, emphasizing the challenges ahead. While Aetna’s departure isn’t a massive loss—serving only a small fraction of Georgia’s 1.5 million […]
Canceled or Renewed 2025: Which TV Shows Will Return?

It’s that time again! With the latest season winding down, the network is unveiling its summer schedule, giving insights into the status of shows that haven’t been canceled or updated yet. Even though it’s only May, I’ve noticed quite a few broadcast and streaming shows making their exits. On the brighter side, the network has […]